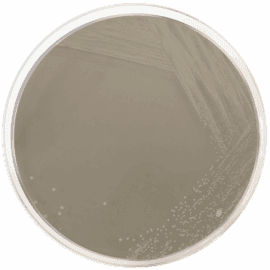
Yeast Extract Peptone Dextrose Mediums Market | Industry Analysis

Yeast Extract Peptone Dextrose Mediums Market | Industry Analysis
Our Latest Yeast Extract Peptone Dextrose Mediums Market Report offers a complete picture of industry trends and factors along with quantitative data based on historical data and from various sources. This report also incorporates a list of major players active in the market along with their market size, share, trends, growth, overview and smart strategy adopted by them. Therefore, this report contains all the important information.
This section of the yeast extract peptone dextrose mediums market report provides detailed data on the segments at country and regional level, thereby assisting the strategist in identifying the target demographics for the respective product or services with the upcoming opportunities.
Request a FREE Sample Copy of Global Yeast Extract Peptone Dextrose Mediums Market Report with Full TOC At: https://www.valuemarketresearch.com/contact/yeast-extract-peptone-dextrose-mediums-market/download-sample
By Type
· Liquid
· Solid
By Application
· Biology
· Laboratory
Browse Full Global Yeast Extract Peptone Dextrose Mediums Market Research Report With TOC At: https://www.valuemarketresearch.com/report/yeast-extract-peptone-dextrose-mediums-market
The research report also covers the comprehensive profiles of the key players in the market and an in-depth view of the competitive landscape worldwide. The major players in the yeast extract peptone dextrose mediums market include Thermo Fisher Scientific, Hardy Diagnostics, SRI International, Himedialabs, Tulip Diagnostics Private Limited, Microxpress, Scharlab, HiMedia Laboratories, Cyrusbioscience. This section consists of a holistic view of the competitive landscape that includes various strategic developments such as key mergers & acquisitions, future capacities, partnerships, financial overviews, collaborations, new product developments, new product launches, and other developments.
This section covers the regional outlook, which accentuates current and future demand for the Yeast Extract Peptone Dextrose Mediums market across North America, Europe, Asia-Pacific, Latin America, and Middle East & Africa. Further, the report focuses on demand, estimation, and forecast for individual application segments across all the prominent regions.
Purchase complete Global Yeast Extract Peptone Dextrose Mediums Market Research Report At: https://www.valuemarketresearch.com/contact/yeast-extract-peptone-dextrose-mediums-market/buy-now
About Us:
Value Market Research was established with the vision to ease decision making and empower the strategists by providing them with holistic market information.
We facilitate clients with syndicate research reports and customized research reports on 25+ industries with global as well as regional coverage.
Contact:
Value Market Research
401/402, TFM, Nagras Road, Aundh, Pune-7.
Maharashtra, INDIA.
Tel: +1-888-294-1147
Email: sales@valuemarketresearch.com
Website: https://www.valuemarketresearch.com
VMR News: https://www.vmrnews.com
Appreciate the creator